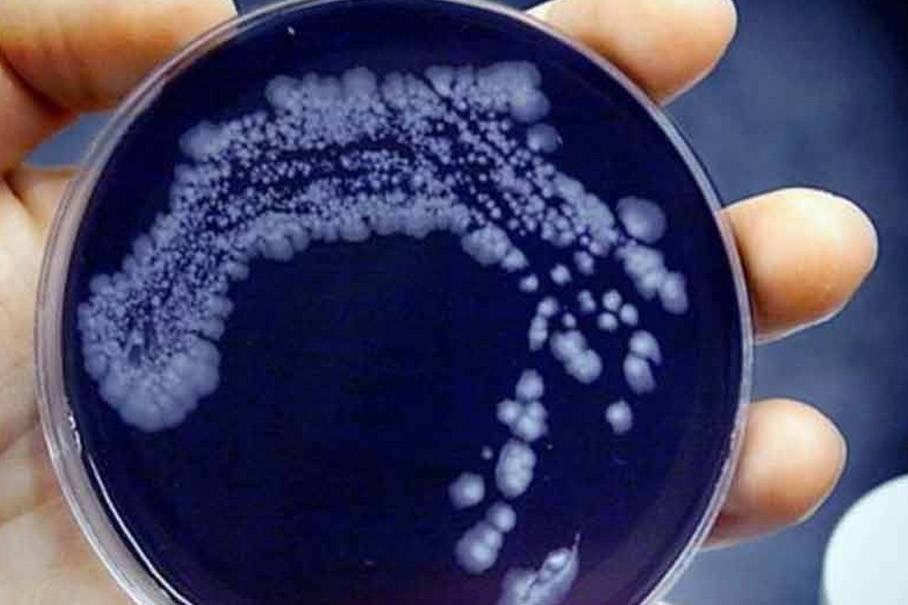

IMPACTO DE LA METEOROLOGÍA SOBRE LA LEGIONELLA Y LA ENFERMEDAD DEL LEGIONARIO
28 Enero, 2026
Son numerosos los estudios que históricamente han buscado la relación entre la enfermedad del legionario (LD) y los fenómenos meteorológicos, especialmente con la temperatura, la humedad y la pluviometría.
Ahora se ha publicado un estudio realizado en Cataluña por Elisenda Arqué y colaboradores para analizar la asociación entre la temperatura del agua en las muestras de agua, la temperatura atmosférica, la precipitación acumulada y la humedad relativa con la presencia de Legionella en las muestras de agua, así como la incidencia de LD.
Para ello, se analizaron un total de 32.179 muestras de agua recogidas durante seis años. La mayoría de las muestras se tomaron de agua caliente sanitaria (48,56 %), torres de refrigeración (18,92 %) y de agua fría de consumo (14,18 %). Las aguas recreativas (jacuzzis, spas,…), máquinas barredoras, dispositivos de rociadores, lavaderos de coches, fuentes de agua ornamentales, sistemas contra-incendios y otras instalaciones representaron el 18,34 % del total de muestras.
Durante el transcurso del período de estudio, la tasa de positividad global de Legionella en los análisis periódicos aumentaron significativamente en un 32,41 %, desde el 6,51 % en 2018 al 8,62 % en 2023.
Paralelamente, los casos de LD en Cataluña aumentaron durante el período del estudio de 5,74 a 7,49 casos por cada 100.000 habitantes en 2018 y 2023, respectivamente, lo que representa un aumento del 30,49 %.
L. pneumophila serogrupo 2-14 fue el grupo más frecuente (49,84 %) y el serogrupo 1 fue del 38,12 %, muy por encima de otras Legionella spp. (12,04 %). Estas proporciones no variaron mucho entre 2018 y 2023.
Como se aprecia, este porcentaje es casi idéntico al aumento de la positividad de Legionella en muestras tomadas de sistemas hídricos durante el mismo período.
La incidencia de LD parece mostrar un patrón de fluctuación estacional alcanzando su punto máximo dos meses después de las temperaturas atmosféricas de verano. Respecto a las lluvias, no se observó una asociación aparente entre los casos de LD y las lluvias, aunque hay que valorar que Cataluña sufrió una sequía durante parte del período de estudio, que duró de 2021 a 2024.
Cuando los datos de estas variables climáticas se analizan globalmente, no parece haber ninguna relación aparente entre las temperaturas atmosféricas registradas y la positividad de las muestras. Es importante tener en cuenta que las muestras de agua caliente, que representaron el 48,56 % de todas las muestras, no pueden verse afectados por la temperatura atmosférica, ya que están diseñados para generar su propio calor y mantener el agua en el sistema dentro de un rango de temperatura concreta. Sin embargo, cuando se excluye la ACS, positividad de la muestra tendió a aumentar en los meses más cálidos, mientras que en los meses más fríos disminuyeron.
Conclusiones del estudio.
En el estudio, se han analizado las posibles relaciones entre la temperatura del agua en los sistemas de agua, la temperatura atmosférica, la precipitación acumulada y la humedad relativa, por un lado, y, por otro, la presencia y el tipo de Legionella en esas instalaciones y la incidencia de LD.
Los hallazgos sugieren una correlación positiva entre la temperatura atmosférica y la colonización de Legionella en sistemas de agua fría y las torres de refrigeración. También se detectó una correlación positiva entre las temperaturas atmosféricas y la incidencia de LD y una correlación inversa con la humedad relativa.
Finalmente, el estudio afirma que cuando las temperaturas atmosféricas aumentan, el resultado puede ser la creación de condiciones óptimas para el crecimiento bacteriano en los sistemas de agua.
El cambio climático está aumentando la probabilidad de que tales condiciones óptimas ocurran en los sistemas de agua y también que persistan durante períodos de tiempo más largos, aumentando así el número de las instalaciones en riesgo para dispersar Legionella a través de aerosoles y causar infecciones entre la población.
Como resultados, se sugiere que, en Cataluña, los factores meteorológicos están asociados con la colonización de los sistemas de agua por Legionella y la incidencia de LD. Este estudio destaca que a medida que avanza el cambio climático, es probable que se observe un aumento en la incidencia de LD.
Descarga el estudio